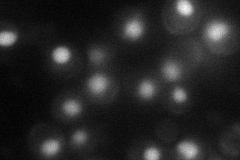
YER013W
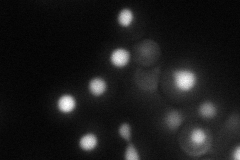
YER013W

View description
DEAH-box RNA-dependent ATPase/ATP-dependent RNA helicase, associates with lariat intermediates before the second catalytic step of splicing; mediates ATP-dependent mRNA release from the spliceosome and unwinds RNA duplexes
Localization:
Intensity:
Fold change:
Significance:
-
C’ GFP library in SD

nucleus23.82 -
N' NOP1pr-GFP in SD
nucleus43.6465 -
N' TEF2pr-mCherry in SD
nucleus40.8428 -
N' NATIVEpr-GFP in SD

nucleus24.325 -
N' TEF2pr-VC and Cyto-VN in SD

nucleus27.8144 -
C’ GFP library in SD+DTT

nucleus24.051No -
C’ GFP library in SD+H2O2

nucleus26.921.12No -
C’ GFP library in Starvation Media

nucleus20.010.84No -
C’ GFP library on the background of Pup2-DaMP

nucleus -
C’ GFP library on the background of CCT mutant

nucleus26.58961.11587No
